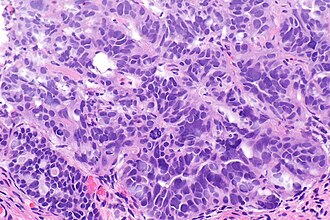

Serous carcinoma of the fallopian tube
Jump to navigation
Jump to search
| Serous carcinoma of the fallopian tube | |
|---|---|
| Diagnosis in short | |
Micrograph of fallopian tube serous carcinoma. H&E stain. | |
| LM DDx | other serous carcinomas (e.g. serous carcinoma of the ovary), serous tubal intraepithelial carcinoma |
| Site | fallopian tube |
|
| |
| Radiology | adnexal mass |
| Prognosis | usually poor |
| Clin. DDx | ovarian cancer, ovarian tumours |
Serous carcinoma of the fallopian tube is a serous carcinoma that arise from the Fallopian tube. These are thought to be important in the development of ovarian cancer.[1]
General
May be associated with germline mutations in:[1]
- BRCA1.
- BRCA2.
- ATM.
- PALB2.
- BRIP1.
Microscopic
DDx:
- Other serous carcinomas, e.g. serous carcinoma of the ovary.
- Serous tubal intraepithelial carcinoma.
Images
See also
References
- ↑ 1.0 1.1 Samuel D, Diaz-Barbe A, Pinto A, Schlumbrecht M, George S (February 2022). "Hereditary Ovarian Carcinoma: Cancer Pathogenesis Looking beyond BRCA1 and BRCA2". Cells 11 (3). doi:10.3390/cells11030539. PMC 8834207. PMID 35159349. https://www.ncbi.nlm.nih.gov/pmc/articles/PMC8834207/.





